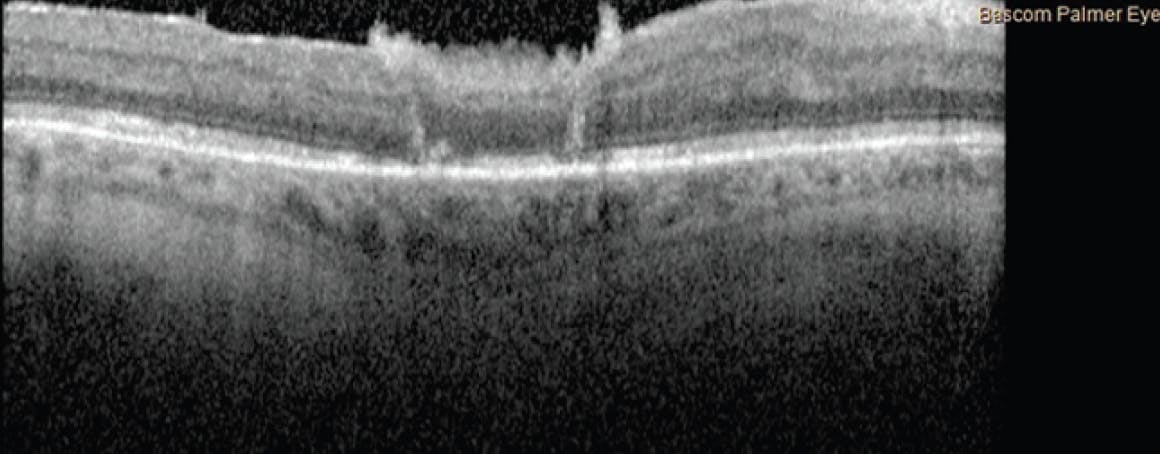
<p>Figure 5. OCT imaging obtained 13 days after the procedure and staged PFO removal demonstrates that the macular hole remained closed. The patient’s VA was 20/70 OD.</p>

Primary full-thickness macular holes (FTMHs) most commonly develop in elderly patients withoutapparent underlying retinal diseases. Recentstudies that include OCT imaging have attributed theformation of an idiopathic FTMH to the persistent adherence of the cortical vitreous to the fovea, which causes vitreoretinal separation.1-3 The resulting traction on the fovea is also thought to contribute to cystoid degeneration and dissolution of inner retinal layers, which may lead to fovealdetachment or dehiscence and FTMH formation.4-6
Another proposed mechanism of FTMH involves tangential traction from an adherent posterior hyaloid or from the presence of an epiretinal membrane, which can exert tangential traction on the fovea and generate an FTMH.7,8
The current standard surgical management for primary FTMH is pars plana vitrectomy (PPV) with internal limiting membrane (ILM) peeling and the use of a tamponade agent, which achieves a closure rate of greater than 90%.9,10
If the macular hole does not close with the standard approach, there are several unique strategies that can help, including the inverted ILM flap with or without adjuvant blood products, lens capsule flap transplantation, human amniotic membrane, and autologous retinal transplantation (ART).10-12 Here we present an example of a refractory FTMH successfully closed after multiple failed surgeries, leading to meaningful visual acuity improvement.
CASE PRESENTATION
A 60-year-old man with a medical history of diabetes, hyperlipidemia, hypertension, and neovascular glaucoma in the left eye presented for a second opinion. He had developed an FTMH in his only seeing eye—the right eye—3 months prior and had undergone three unsuccessful PPV procedures with ILM peel and gas tamponade. His VA was counting fingers OD. OCT demonstrated an FTMH measuring approximately 1,000 µm with underlying retinal pigment epithelium (RPE) atrophy and no visible posterior hyaloid face (Figure 1). Alternative surgical options were discussed with the patient.

Figure 1. OCT imaging showed a refractory primary FTMH of approximately 1,000 µm in the right eye of a 60-year-old man with a VA of counting fingers.
TREATMENT OPTIONS
The inverted ILM flap technique involves performing a core vitrectomy and trypan blue staining followed by peeling any epiretinal membrane; ILM forceps are used to peel the membrane in a circular fashion around the macular hole.13 While performing the circumferential peeling, the surgeon aims to leave the ILM attached to the edges of the macular hole. The rolled segment of the peeled ILM is massaged gently over the macular hole until the ILM is inverted so the surface that normally faces the vitreous body now faces the RPE.13 Michalewska et al reported great success with this technique; they stated that the technique was able to achieve a high closure rate in myopic macular holes and led to a mean improvement in VA of 6 logMAR lines.13
Lens capsule flap transplantation involves harvesting a piece of the anterior or posterior lens capsule and placing it into the hole to help facilitate hole closure.14 Chen at el found that the macular hole was closed in all 10 eyes undergoing anterior capsular flap transplantation. Comparatively, in the 10 patients who underwent posterior capsular flap transplantation, five holes were closed, three were partially closed, and two were not closed.14 Peng et al recently described the long-term outcomes of lens capsule flap transplantation as a primary treatment for large macular holes and found promising results.15
Consequently, not only can lens capsule flap transplantation be effective in treating refractory macular holes, but it also may help improve the closure rate and visual outcomes when used as the primary treatment for large macular holes.15
Human amniotic membrane use has been proposed as a method to address failed macular hole closure.16 Amniotic membrane has a wide variety of biomedical applications, but its use in the treatment of refractory macular holes has not been studied extensively.17 Several case reports and small series show promising initial results for the use of amniotic membrane in the closure of refractory macular holes.18-21
Several studies have described ART as an effective option for FTMH closure.12,22-25 The surgical technique involves selecting an appropriate graft size, depending on the FTMH defect size, and neurosensory retina harvest site, typically in the midperiphery superior to the superotemporal arcade. Once the harvest site is selected according to surgeon preference in the superior, temporal, or nasal location beyond the arcade, diathermy is used to mark the autograft site. Vertical scissors are used to free the graft tissue, and endolaser barricade is applied in a circular manner around the graft site. PFO is then injected, and the graft is moved toward the macular hole with grasping forceps and positioned with a loop scraper. The patient is positioned supine postoperatively, and PFO is removed 7 to 10 days later. In clinical studies, the ART technique offered a high degree of anatomic closure of refractory macular holes, with closure rates ranging from 87% and 89% to 100%.12,22-25
Several studies have examined the use of adjunctive treatments, such as recombinant TGF-ß2 or platelet products such as autologous platelets, platelet-rich plasma, and platelet-derived growth factor.11,26-28 The results of one study examining recombinant TGF-ß2 demonstrated no difference between the application of TGF-ß2 and placebo in closing FTMHs; however, platelet-derived products have proven to be efficacious as an adjunctive treatment for closure of macular holes.26-28
SURGICAL OUTCOME
The patient presented here elected to undergo ART for refractory primary FTMH. He failed to position as instructed, and on postoperative day 1, the patient had a VA of 20/250 with a dislocated graft and a persistent FTMH (Figure 2).
The patient was eager to undergo a second attempt, which was performed 1 week later. Imaging obtained 1 day after the second ART procedure showed the hole to be adequately covered by the graft under PFO tamponade (Figure 3). His VA was 3/200 OD. Repeat OCT demonstrated an adequately positioned graft and closed macular hole (Figure 4).

Figure 3. The color fundus photograph obtained 1 day after the second surgery depicted two graft harvest sites with the macular hole adequately covered by the graft and PFO present in the eye. The patient’s VA was 3/200 OD.

Figure 4. OCT imaging 1 day after the second procedure depicted the graft in an adequate position and a closed macular hole.
On postoperative day 13, after staged PFO removal, repeat OCT demonstrated that the macular hole remained closed, and the patient’s VA was 20/70 OD (Figure 5).
Figure 5. OCT imaging obtained 13 days after the procedure and staged PFO removal demonstrates that the macular hole remained closed. The patient’s VA was 20/70 OD.
One month after the second surgery, the macular hole remained closed, and the patient’s VA had improved to 20/50 OD (Figure 6).

Figure 6. OCT imaging obtained 31 days after the second procedure showed that the macular hole remained closed. The patient’s VA was 20/50.
This case demonstrates the effectiveness of ART in patients with refractory macular holes after undergoing PPV with or without ILM peeling. Preoperative discussions are a must to ensure patients understand the importance of adhering to postoperative positioning instructions to minimize the chances of graft dislocation. With appropriate patient selection, ART may be a viable option for closure of refractory FTMHs.
1. Haouchine B, Massin P, Gaudric A. Foveal pseudocyst as the first step in macular hole formation: a prospective study by optical coherence tomography. Ophthalmology. 2001;108(1):15-22.
2. Johnson MW. Improvements in the understanding and treatment of macular hole. Curr Opin Ophthalmol. 2002;13(3):152-160.
3. Hussain N, Hussain A, Natarajan S. Optical coherence tomographic evaluation of foveal pseudocyst in the formation of macular hole. Indian J Ophthalmol. 2003;51(4):353-355.
4. Gass JD. Idiopathic senile macular hole. Its early stages and pathogenesis. Arch Ophthalmol. 1988;106(5):629-639.
5. Gordon LW, Glaser BM, Ie D, Thompson JT, Sjaarda RN. Full-thickness macular hole formation in eyes with a pre-existing complete posterior vitreous detachment. Ophthalmology. 1995;102(11):1702-1705.
6. Yeh PT, Chen T-C, Yang C-H, et al. Formation of idiopathic macular hole-reappraisal. Graefes Arch Clin Exp Ophthalmol. 2010;248(6):793-798.
7. Steel DH, Lotery AJ. Idiopathic vitreomacular traction and macular hole: a comprehensive review of pathophysiology, diagnosis, and treatment. Eye (Lond). 2013;27(suppl 1):S1-S21.
8. Tsai CY, Hsieh Y-T, Lai T-T, Yang C-M. Idiopathic macular holes and direction of vitreomacular traction: structural changes and surgical outcomes. Eye (Lond). 2017;31(12):1689-1696.
9. Ko TH, Witkin AJ, Fujimoto JG, et al. Ultrahigh-resolution optical coherence tomography of surgically closed macular holes. Arch Ophthalmol. 2006;124(6):827-836.
10. Charles S, Randolph JC, Neekhra A, Salisbury CD, Littlejohn N, Calzada JI. Arcuate retinotomy for the repair of large macular holes. Ophthalmic Surg Lasers Imaging Retina. 2013;44(1):69-72.
11. Thompson JT, Smiddy WE, Williams GA, et al. Comparison of recombinant transforming growth factor-beta-2 and placebo as an adjunctive agent for macular hole surgery. Ophthalmology. 1998;105(4):700-706.
12. Grewal DS, Charles S, Parolini B, Kadonosono K, Mahmoud TH. Autologous retinal transplant for refractory macular holes: multicenter international collaborative study group. Ophthalmology. 2019;126(10):1399-1408.
13. Michalewska Z, Michalewski J, Dulczewska-Cichecka K, Nawrocki J. Inverted internal limiting membrane flap technique for surgical repair of myopic macular holes. Retina. 2014;34(4):664-669.
14. Chen SN, Yang CM. Lens capsular flap transplantation in the management of refractory macular hole from multiple etiologies. Retina. 2016;36(1):163-170.
15. Peng J, Chen C, Zhang L, et al. Lens capsular flap transplantation as primary treatment for closure of large macular holes. Retina. 2022;42(2):306-312.
16. Caporossi T, Pacini B, Bacherini D, Barca F, Faraldi F, Rizzo S. Human amniotic membrane plug to promote failed macular hole closure. Sci Rep. 2020;10(1):18264.
17. Tehrani FD, Firouzeh A, Shabani I, Shabani A. A review on modifications of amniotic membrane for biomedical applications. Front Bioeng Biotechnol. 2020;8:606982.
18. Romano MR, Rossi T, Borgia A, Catania F, Sorrentino T, Ferrara M. Management of refractory and recurrent macular holes: a comprehensive review. Surv Ophthalmol. 2022;67(4):908-931.
19. Bamberger MD, Felfeli T, Politis M, Mandelcorn ED, Galic IJ, Chen JC. Human amniotic membrane plug for chronic or persistent macular holes. Ophthalmol Retina. 2022;6(5):431-433.
20. Abdul-Kadir MA, Lim LT. Update on surgical management of complex macular holes: a review. Int J Retina Vitreous. 2021;7(1):75.
21. Caporossi T, Governatori L, Verdina T, Rizzo S. Human amniotic membrane for failed macular hole. A case of initial unsuccessful outcome that resolved after amniotic membrane exchange. Eur J Ophthalmol. 2021:11206721211058996.
22. Tanaka S, Inoue M, Inoue T, et al. Autologous retinal transplantation as a primary treatment for large chronic macular holes. Retina. 2020;40(10):1938-1945.
23. Parolini B, Grewal DS, Pinackatt SJ, et al. Combined autologous transplantation of neurosensory retina, retinal pigment epithelium, and choroid free grafts. Retina. 2018;38(suppl 1):S12-S22.
24. Moysidis SN, Koulisis N, Adrean SD, et al. Autologous retinal transplantation for primary and refractory macular holes and macular hole retinal detachments: The Global Consortium. Ophthalmology. 2021;128(5):672-685.
25. Sanjuan P, Samaan M, Nadal J. Autologous retina transplantation for treatment of refractory double full-thickness macular hole in Alport syndrome [Preprint published online January 13, 2021]. Retin Cases Brief Rep.
26. Babu N, Kohli P, Ramachandran NO, Adenuga OO, Ahuja A, Ramasamy K. Comparison of platelet-rich plasma and inverted internal limiting membrane flap for the management of large macular holes: a pilot study. Indian J Ophthalmol. 2020;68(5):880-884.
27. Yang YH, Chung YT, Kim BK, Moon JH, Mun SJ. Inverted internal limiting membrane flap technique and an autologous platelet concentrate to treat an Nd: YAG laser-induced macular hole: a case report. Medicine (Baltimore). 2019;98(47):e18185.
28. Ch’ng SW, Elaraoud I, Karl D, Kalogeropoulos D, Lee R, Carreras E. A combination of surgical techniques to repair a giant traumatic macular hole. Case Rep Ophthalmol Med. 2018;2018:7595873.

























